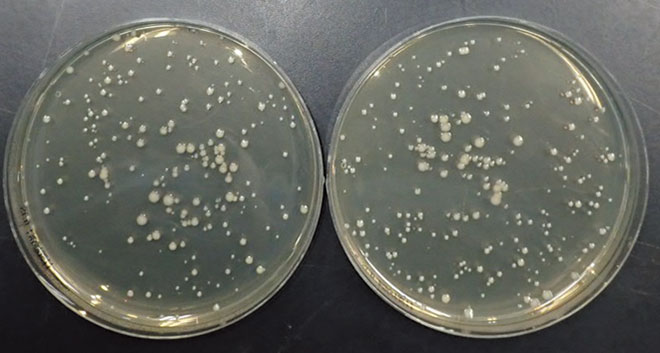
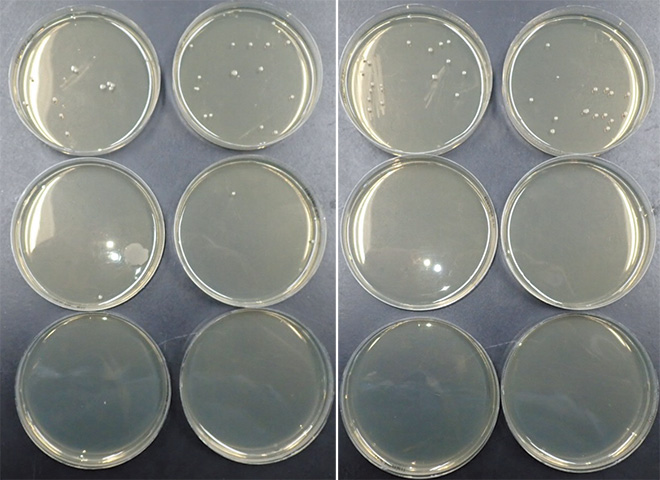

納入事例
殺菌・滅菌システム 表面の殺菌
新潟県工業技術総合研究所 素材応用技術支援センター新潟県見附市
マスクの殺菌試験で活躍する「パルスドキセノン殺菌装置」
Myリストに追加お客さまの声:新潟県工業技術総合研究所 素材応用技術支援センター/明歩谷 英樹様
新潟県工業技術総合研究所は、県内企業が直面する技術課題の解決を支援し、ものづくりの基盤技術や先進的な産業技術に関する研究開発を通じて、新潟県産業の発展と成長を企業とともに目指す技術支援機関です。見附市にある素材応用技術支援センターは、県内6か所の技術支援センターの一つで、県内産業の技術高度化並びに高付加価値化を図るため、地域の企業への技術支援をはじめ、広く技術サービスを行っています。
当センターには、依頼試験や機器貸付、ミニ共同研究などに対応する各種試験機器が揃っていて、2021年2月には、新たに「パルスドキセノン殺菌装置」を導入しました。新型コロナウイルス対策としてマスク生産事業の立ち上げを検討されている県内企業を支援するため、マスクに使用する不織布の性能試験を行う目的で設置したものです。「パルスドキセノン殺菌装置」の採用については、たとえばオートクレーブ滅菌(高圧蒸気滅菌)の場合、試験品が熱や水分に弱い場合には向かず、高温で30分程と時間もかかるのに比べ、乾式で高殺菌能力を持つキセノンランプの強力な光を使って瞬時に効率よく菌を殺菌できる点を評価のうえ、導入を決定しました。殺菌試験は、黄色ブドウ球菌をSCD寒天培地上に塗布して「パルスドキセノン殺菌装置」内で照射を行い、殺菌効果を確認するという方法で実施しており、充電電圧2.8kVの1回照射でも91.2%の殺菌効果があることを確認できています。現在は予備実験の段階で、運用に向けて調整・準備をしているところです。
試験品への影響が少なく、信頼性の高い殺菌試験を行うことで、絹織物やニット製品など、全国に誇る高い技術と品質を持つ新潟県の繊維産業が取り組むマスク生産事業を支援する一助となるものと考えています。
主な納入器具
パルスドキセノン殺菌装置 - 1台